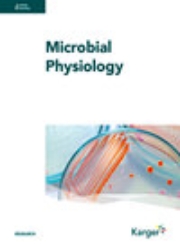

- 充值
- 会员
- 职称材料
搜期刊
刊名
文献信息
- 任意字段
- 主题词
- 篇关摘
- 篇名
- 关键词
- 摘要
- 作者
- 第一作者
- 作者单位
- 刊名
- 中图分类号
- 学科分类号
- DOI
- 基金
首字母查找:
0-9
A
B
C
D
E
F
G
H
I
J
K
L
M
N
O
P
Q
R
S
T
U
V
W
X
Y
Z
共有 2,567 个结果,以下是801 - 820条
41 / 129
相关度
发文量
影响因子
发文量
926
\
被引量
35,389
\
影响因子(2025版)
5.805
发文量
2,428
\
被引量
35,254
\
影响因子(2025版)
0.418
发文量
1,018
\
被引量
34,856
\
影响因子(2025版)
1.333
发文量
2,334
\
被引量
34,844
\
影响因子(2025版)
1.887
发文量
1,451
\
被引量
34,580
\
影响因子(2025版)
4.374
发文量
541
\
被引量
34,476

德国
主办单位:WILEY
出版周期: 连续出版
别名: J ZOOL SYST EVOL RES;J. Zool. Syst. Evol. Res.;Journal of Zoological Systematics & Evolutionary Research;JOURNAL OF ZOOLOGICAL SYSTEMATICS AND EVOLUTIONARY RESEARCH;Journal of zoological systematics and evolutionary research;Zeitschrift für zoologische Systematik und Evolutionsforschung
ISSN 0947-5745 / EISSN 1439-0469
发文量
1,923
\
被引量
34,464
\
影响因子(2025版)
2.273
发文量
2,238
\
被引量
34,352
\
影响因子(2025版)
2.325
发文量
1,018
\
被引量
34,256
\
影响因子(2025版)
3.760
发文量
449
\
被引量
34,092
发文量
9,433
\
被引量
34,081
\
影响因子(2025版)
0.215
发文量
2,139
\
被引量
33,929
\
影响因子(2025版)
1.050
发文量
1,372
\
被引量
33,497
\
影响因子(2025版)
1.550
发文量
2,164
\
被引量
33,492
\
影响因子(2025版)
1.130
发文量
2,304
\
被引量
33,461
\
影响因子(2025版)
0.357
发文量
3,884
\
被引量
33,232
\
影响因子(2025版)
2.551
发文量
1,072
\
被引量
33,182
发文量
1,046
\
被引量
33,083
\
影响因子(2025版)
2.761
发文量
4,683
\
被引量
33,042
\
影响因子(2025版)
0.366
发文量
2,638
\
被引量
32,925
\
影响因子(2025版)
0.872
- 1
- 39
- 40
- 41
- 42
- 43
- 129
重庆维普资讯有限公司
渝B2-20050021-1 渝公网备 50019002500403
违法和不良信息举报中心 举报邮箱:jubao@cqvip.com 互联网算法推荐专项举报:sfjubao@cqvip.com
网络暴力专项举报: bljubao@cqvip.com
网络出版:(署)网出证(渝)字第014号
出版物经营许可证:新出发2018批字第006号
关于旧版官网用户迁移的说明